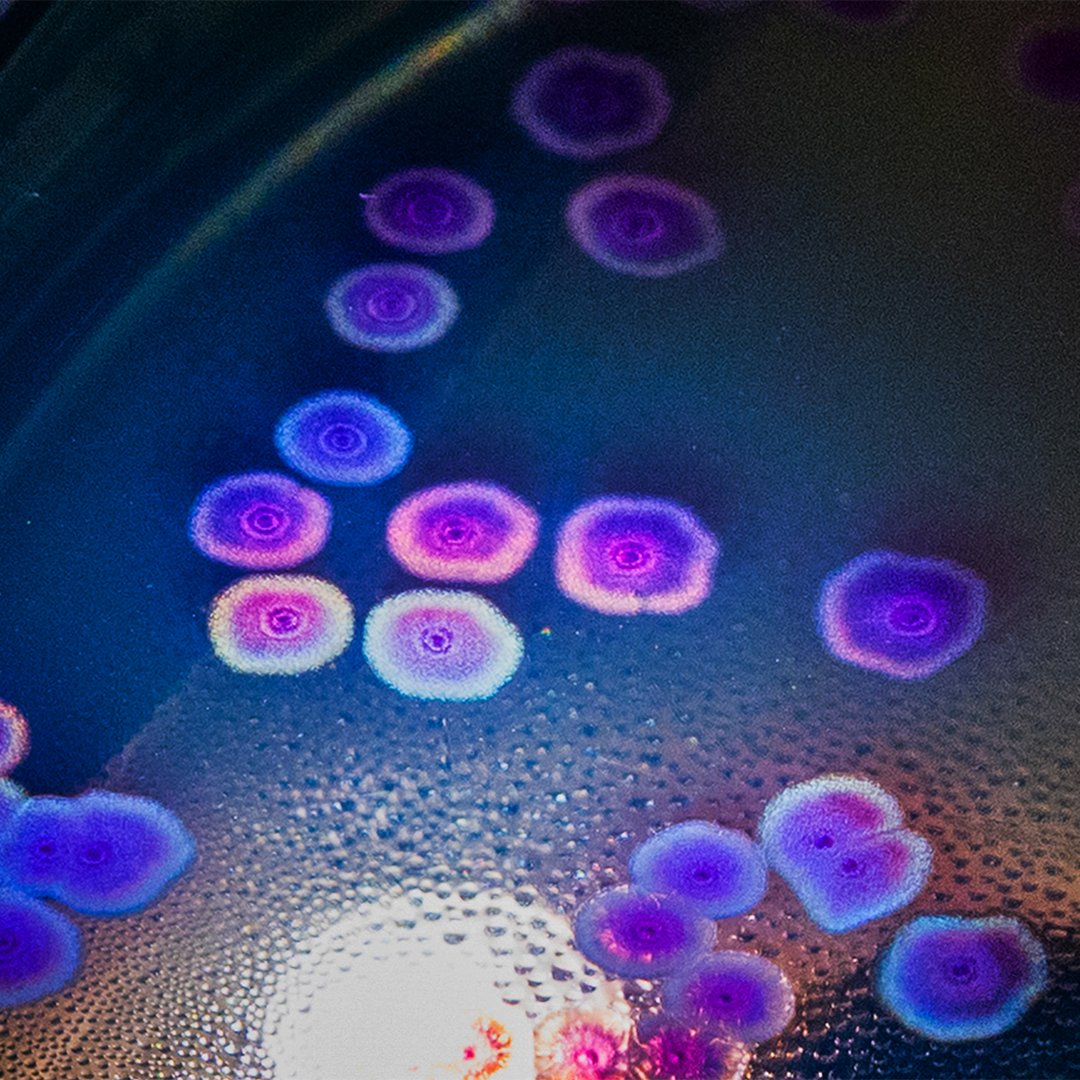

Born from a deep respect for science and an obsession with aesthetics, this project transforms infectious disease bacteria into visual icons — not to romanticize, but to reframe.
Each image you’ll find here is rooted in biological truth and shaped by artistic intention.
These visuals offer more than just form — they offer a new way of seeing.
This gallery invites you to experience the microbial world as it truly is: elegant, essential, and alive with meaning.
Begin your journey below.